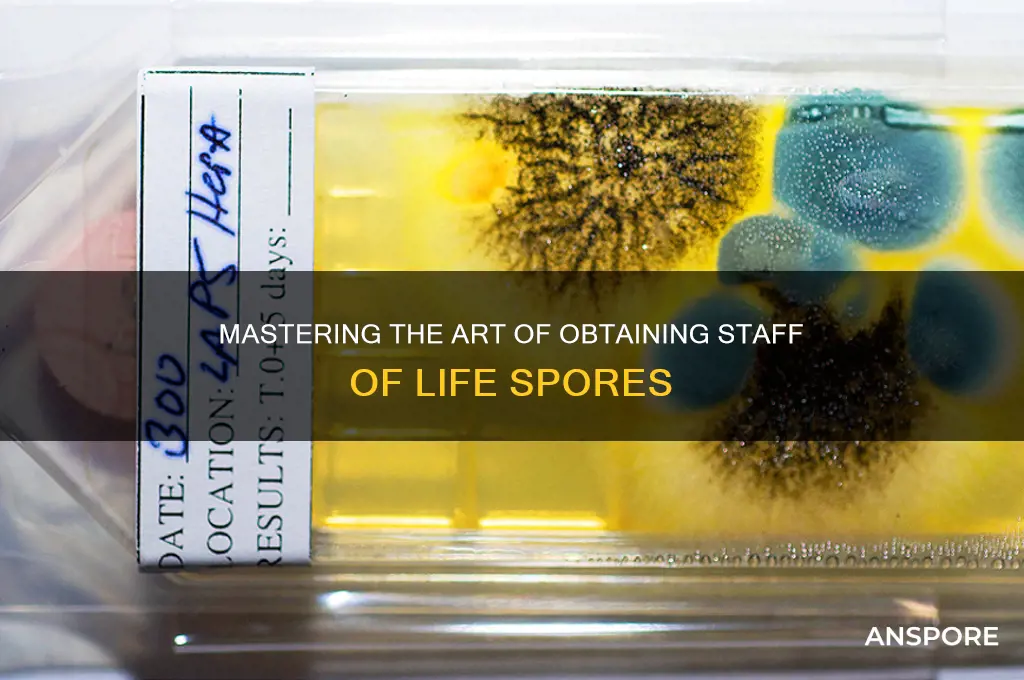
how to get staff of life spore

The Staff of Life spore is a highly sought-after item in the world of gaming, particularly in titles like *Don’t Starve Together*, where it serves as a crucial ingredient for crafting powerful items. Obtaining this rare spore requires a combination of strategy, patience, and knowledge of the game’s mechanics. Players must first locate a Living Log, a unique creature that spawns in specific biomes, and then nurture it by feeding it twigs until it transforms into a Living Tree. Once the tree is fully grown, it has a chance to drop the Staff of Life spore when harvested. Success hinges on understanding the game’s resource management, timing, and the specific conditions needed to trigger the spore’s appearance, making it a rewarding challenge for dedicated players.
| Characteristics | Values |
|---|---|
| Item Name | Staff of Life Spore |
| Game | Final Fantasy XI |
| Type | Gardening Item |
| Obtained From | Harvesting specific plants in a garden |
| Required Plants | Wild Oat, Silkworm Pupa, or Pumpkin (mature and ready for harvest) |
| Harvest Time | After the plant reaches 100% growth and is ready for harvest |
| Rarity | Rare (not guaranteed from every harvest) |
| Use | Used to create the Staff of Life (a powerful weapon) through synthesis |
| Synthesis Recipe | Staff of Life Spore + Mythril Ingot + Darksteel Bolt + Water Crystal (synthesized by a skilled Blacksmith) |
| Notes | Success rate for obtaining the spore varies; gardening skill and plant care affect chances. |
What You'll Learn
- Farming Locations: Find Staff of Life in lush, grassy areas like forests, meadows, and near water sources
- Optimal Conditions: Ensure high humidity, moderate light, and fertile soil for spore growth
- Harvesting Techniques: Gently collect spores using a fine brush or sterile tool to avoid contamination
- Storage Methods: Store spores in airtight containers in a cool, dark place for longevity
- Cultivation Tips: Use nutrient-rich substrates and maintain consistent moisture for successful spore cultivation

Farming Locations: Find Staff of Life in lush, grassy areas like forests, meadows, and near water sources
Lush, grassy environments teem with the conditions necessary for Staff of Life spores to thrive. These spores favor areas rich in organic matter, moisture, and sunlight—elements abundant in forests, meadows, and regions near water sources. When scouting for these spores, prioritize locations where grass grows thick and vibrant, as this indicates a fertile substrate conducive to spore development. Avoid over-trodden or barren patches, as these are less likely to yield results.
To maximize your chances, time your search during the early morning or late afternoon when humidity levels are higher. Staff of Life spores often cling to dew-covered grass blades, making them easier to spot and collect. Equip yourself with a fine-bristled brush and a small container with a lid to gently gather spores without damaging their delicate structure. Be patient and methodical; spores are microscopic, so thorough inspection of each area is key.
Comparing farming locations reveals distinct advantages. Forests offer shade and consistent moisture, ideal for spores that prefer indirect sunlight. Meadows, on the other hand, provide expansive open spaces where sunlight penetrates fully, fostering rapid spore growth. Areas near water sources, such as riverbanks or lakesides, combine the benefits of both, offering ample moisture and nutrient-rich soil. Tailor your search based on the specific needs of the Staff of Life spore variety you’re targeting.
A practical tip for beginners: mark your most successful collection spots with discreet, eco-friendly markers. This ensures you can return to proven locations without disturbing the ecosystem. Additionally, rotate your farming areas to prevent over-harvesting, which could deplete spore populations. By respecting the environment, you sustain both the spores and your ability to collect them long-term.
Mastering Spore's Fishing Mechanics: Tips and Tricks for Success
You may want to see also

Optimal Conditions: Ensure high humidity, moderate light, and fertile soil for spore growth
Spores of the Staff of Life, a term often associated with certain fungi or plants, thrive under specific environmental conditions. To cultivate these spores successfully, one must replicate their natural habitat, which typically demands high humidity, moderate light, and nutrient-rich soil. These conditions are not arbitrary; they are the result of evolutionary adaptations that ensure the spores’ survival and proliferation. High humidity prevents desiccation, a critical factor for spore germination, while moderate light provides the energy needed for initial growth without causing stress. Fertile soil, rich in organic matter, supplies the essential nutrients required for robust development.
Creating the ideal environment begins with humidity control, which should be maintained between 70% and 90%. This can be achieved using a humidifier, misting the area regularly, or enclosing the spores in a humidity-controlled chamber. For small-scale cultivation, placing a tray of water near the spores or using a clear plastic dome to trap moisture are practical solutions. It’s crucial to monitor humidity levels with a hygrometer to avoid fluctuations that could hinder germination. Overly dry conditions can render spores dormant, while excessive moisture may lead to mold or rot.
Light exposure must be carefully managed to support spore growth without overwhelming the delicate structures. Moderate, indirect light is ideal, mimicking the dappled sunlight found in their natural forest habitats. For indoor cultivation, fluorescent or LED grow lights set to a 12-14 hour photoperiod work well. Avoid direct sunlight, as it can scorch the spores and deplete soil moisture too quickly. If natural light is used, filter it through sheer curtains or place the spores in a north-facing window to ensure gentle illumination.
Soil fertility is the foundation of successful spore cultivation. A well-draining, nutrient-dense medium is essential, typically composed of a mix of compost, peat moss, and perlite. Adding a small amount of worm castings or a balanced organic fertilizer can further enrich the soil, providing a steady supply of nutrients. pH levels should be maintained between 6.0 and 7.0, as spores are sensitive to acidity or alkalinity. Regularly testing the soil with a pH meter and adjusting with lime or sulfur ensures optimal conditions for nutrient uptake.
In practice, combining these elements requires attention to detail and consistency. For instance, misting the soil twice daily can maintain humidity while preventing waterlogging. Positioning grow lights at a distance of 12-18 inches ensures adequate light without overheating. Rotating the spore container weekly promotes even growth and prevents leaning toward the light source. By meticulously managing these conditions, cultivators can create an environment where Staff of Life spores not only germinate but flourish, yielding healthy and vibrant growth.
Cultivating Faith in Singapore: A Guide to Religious Practice in the City-State
You may want to see also

Harvesting Techniques: Gently collect spores using a fine brush or sterile tool to avoid contamination
The delicate nature of spores demands precision in harvesting to ensure viability and purity. A fine brush, akin to those used in miniature painting, becomes an essential tool for this task. Its soft bristles allow for gentle collection, minimizing damage to the spore structure. Alternatively, a sterile scalpel or spatula can be employed, especially when dealing with larger spore clusters, but requires a steady hand to avoid contamination from skin contact or environmental factors.
Imagine a mature mushroom cap, its underside a labyrinth of gills teeming with microscopic spores. Using a brush, gently stroke the gill surface, capturing the spores like a painter collecting pigment. This method, though time-consuming, ensures a high yield of uncontaminated spores, crucial for successful cultivation or research. For those seeking efficiency, a sterile tool can be used to carefully scrape the spore mass, but this technique demands precision to avoid damaging the delicate spores or introducing foreign particles.
The choice of tool depends on the spore type and desired yield. For example, the Staff of Life mushroom, known for its robust spores, may tolerate a slightly firmer brush or tool, while more delicate species require the utmost gentleness. Regardless of the tool, sterilization is paramount. Autoclaving or flame sterilization ensures the tool is free from contaminants that could compromise the spore sample.
Beyond tool selection, environmental control is crucial. Harvesting should occur in a clean, controlled environment, ideally a laminar flow hood, to minimize airborne contaminants. Wearing sterile gloves and a mask further reduces the risk of introducing foreign particles. Remember, the goal is to create a pristine environment for spore collection, mimicking the natural conditions that foster their growth.
Practical Tip: For home cultivators, a DIY sterilization setup can be created using a pressure cooker and isopropyl alcohol. While not as effective as autoclaving, it provides a cost-effective solution for small-scale spore harvesting.
True Stems, Roots, and Spores: Exploring Unique Plant Dispersal Methods
You may want to see also

Storage Methods: Store spores in airtight containers in a cool, dark place for longevity
Proper storage is critical for preserving the viability of Staff of Life spores, ensuring they remain potent for future use. Airtight containers are non-negotiable; even minimal exposure to moisture or air can compromise spore integrity. Glass vials with rubber stoppers or vacuum-sealed bags are ideal. Avoid plastic containers unless they’re food-grade and BPA-free, as chemicals can leach over time. Label containers with the date of collection and storage conditions for easy reference.
Temperature and light control are equally vital. Spores thrive in cool environments, ideally between 35°F and 45°F (2°C to 7°C). A refrigerator’s vegetable crisper drawer, insulated from temperature fluctuations, is a practical choice. Darkness is equally important, as light can degrade spore DNA. Wrap containers in opaque material or store them in a light-blocking box if refrigerator lighting is a concern.
Humidity is the silent enemy of spore longevity. Silica gel packets placed inside the storage container can absorb excess moisture, maintaining optimal dryness. For long-term storage, consider desiccants like calcium chloride, but ensure they’re kept in a separate compartment to avoid direct contact with spores. Regularly inspect the desiccant and replace it if it becomes saturated.
While these methods can extend spore life for years, periodic viability testing is recommended. Every 6–12 months, germinate a small sample to assess potency. If germination rates drop below 80%, consider refreshing the storage conditions or using the spores promptly. Proper storage isn’t just about preservation—it’s about ensuring the Staff of Life spores are ready to fulfill their purpose when needed.
Cotton in Ears: Effective Protection Against Mold Spores or Myth?
You may want to see also

Cultivation Tips: Use nutrient-rich substrates and maintain consistent moisture for successful spore cultivation
Successful cultivation of Staff of Life spores hinges on creating an environment that mimics their natural habitat. Nutrient-rich substrates are the cornerstone of this process, providing the essential building blocks for spore germination and mycelial growth. Think of it as laying the foundation for a house – a strong, fertile base is crucial for a thriving structure. Opt for substrates like sterilized grain (rye, wheat, or millet), manure-based compost, or a blend of coconut coir and vermiculite. These materials offer a balanced mix of organic matter, minerals, and moisture retention capabilities, fostering optimal spore development.
Remember, the goal is to replicate the nutrient-dense conditions found in decaying wood or soil, where these spores naturally flourish.
Moisture is the lifeblood of spore cultivation, and consistency is key. Spores require a humid environment to absorb water and initiate growth. Aim for a substrate moisture content of 50-60%, similar to a wrung-out sponge. This ensures enough water for absorption without creating waterlogged conditions that can lead to contamination. Misting the substrate regularly with distilled water helps maintain humidity, but be cautious not to oversaturate. Consider using a humidifier or a humidity-controlled chamber for more precise control, especially in drier climates.
Regularly monitoring moisture levels with a hygrometer is essential, allowing you to adjust your watering schedule accordingly.
While nutrient-rich substrates and consistent moisture are fundamental, successful cultivation also demands attention to other factors. Sterilization is paramount to prevent contamination from competing microorganisms. Autoclaving or pressure cooking substrates before inoculation effectively eliminates unwanted bacteria and fungi. Additionally, maintaining a suitable temperature range (typically 70-75°F) encourages spore germination and mycelial growth. Finally, patience is a virtue in spore cultivation. Allow sufficient time for colonization, as rushing the process can lead to suboptimal results.
With careful attention to these details, you'll be well on your way to successfully cultivating Staff of Life spores and unlocking their unique properties.
Spore Game Price: How Much Does It Cost to Play?
You may want to see also
Frequently asked questions
The Staff of Life Spore is a rare item often found in fantasy games or specific quests. It is typically located in hidden areas, dungeons, or obtained as a reward for completing challenging tasks. Check game guides or community forums for exact locations.
Yes, obtaining the Staff of Life Spore often requires meeting certain in-game conditions, such as reaching a specific level, completing a questline, or having a particular skill or item. Refer to the game's documentation or walkthroughs for details.
It depends on the game's mechanics. In some games, the Staff of Life Spore is bound to the player who obtains it and cannot be traded. In others, it may be transferable. Check the game's rules or consult the community for clarification.

